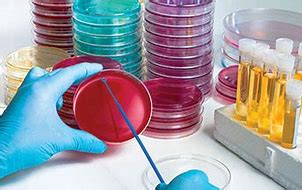

Agar瓊脂USP/EP|Agar Bacteriological No. 1 NEOGEN貨號NCM0214A
| 代理廠牌: |  |
| 原廠連結: | |
| 相關下載: |
6公升迷你培養箱 | 菌液測量 (分光光度計) | 滅菌釜 | 水浴槽WaterBath | 電子天平 | pH酸鹼度計 | Vortex | Pipet aid | Petri dishes 培養皿
微生物之檢驗方法-瓊脂(Agar, Bacteriological No. 1)
瓊脂(Agar, Bacteriological No. 1) | 貨號NCM0214A-符合USP / EP藥典中指定的測試。

產品介紹:.
瓊脂(Agar, Bacteriological No. 1)具有良好的透明度(good clarity,),可控制的膠凝溫度(gelation temperature),可控制的熔化溫度(melting temperature,),良好的擴散特性(good diffusion characteristics),不存在有毒的細菌抑制劑(toxic bacterial inhibitors)以及相對不存在可用於代謝的礦物質(minerals)和化合物(compounds)。瓊脂(Agar, Bacteriological No. 1)建議用於臨床應用,營養缺陷研究,細菌和酵母轉化研究以及細菌分子遺傳學應用。瓊脂(Agar, Bacteriological No. 1) 是一種固化劑,用於在實驗室環境中製備微生物培養基(microbiological culture media)。瓊脂(Agar, Bacteriological No. 1) 符合USP / EP藥典中指定的測試。
瓊脂(Agar, Bacteriological No. 1)是從一組紅紫色藻類(red-purple algae, Gelidium spp)中提取的藻膠體(phycocolloid)。Fannie Hesse於1881年首次提出將瓊脂用於微生物學目的。到1900年代初期,瓊脂(Agar, Bacteriological No. 1)已成為明膠(gelatin)的首選膠凝劑(gelling agent ),因為瓊脂(Agar, Bacteriological No. 1)在許多病原體(pathogens)的生長溫度下仍能保持堅挺,並且瓊脂通常能抵抗細菌酶(bacterial enzymes)的分解。在微生物培養基中使用瓊脂極大地促進了微生物學的發展,為研究純培養物鋪平了道路。瓊脂(Agar, Bacteriological No. 1)在室溫(room temperature)下為凝膠,在高達65°C的溫度下仍保持堅硬。瓊脂在約85-91°C的溫度熔化,與在34-36°C的凝固溫度不同。此屬性稱為磁滯(hysteresis)。
| Specifications | ||
|---|---|---|
| Brand | Neogen® Culture Media | |
| Analyte | General Purpose | |
| Platform | Dehydrated Culture Media | |
| Mass | 5 kg | |
| Previous Item Number | Product was previously known as Acumedia Product: 7178 Agar, Bacteriological | |
| Package Weight | 14.00 lb | |
| Product # | Product Description |
| NCM0214A | Agar, Bacteriological No. 1, 500 g |
| NCM0214B | Agar, Bacteriological No. 1, 5 kg |
| NCM0214C | Agar, Bacteriological No. 1, 10 kg |
更多相關商品 安全核酸染劑商品| Agarose |微生物培養基 | 微生物抗生素 | 質體DNA萃取套組 |Mupid 2 DNA水準電泳槽| 3M微生物快速檢測片
| 貨號 | 品項 |
| NCM0001A | Half Fraser (Demi-Fraser) Broth (ISO) 500g |
| NCM0002A | Tryptic Soy Agar (Soybean-Casein Digest Agar) 500g |
| NCM0003A | Buffered Peptone Water (BPW) 500g |
| NCM0004A | Tryptic Soy Broth (Soybean-Casein Digest Broth) 500g |
| NCM0005A | Lactose Broth 500g |
| NCM0007A | NFL Aseptic Validation Medium 500g |
| NCM0008A | Sabouraud Dextrose Agar 500g |
| NCM0009A | D/E Neutralizing Agar with Tween 500g |
| NCM0010A | Plate Count Agar (Standard Methods) 500g |
| NCM0011A | Tryptic Soy Agar with Lecithin and Tween 80 500g |
| NCM0012A | UVM Broth 500g |
| NCM0013A | Columbia Agar 500g |
| NCM0014A | Fastidious Anaerobe Agar 500g |
| NCM0015A | Buffered Peptone Water (BPW) (ISO) 500g |
| NCM0016A | Brain Heart Infusion Broth 500g |
| NCM0017A | MacConkey Agar 500g |
| NCM0018A | Potato Dextrose Agar 500g |
| NCM0019A | Tryptone Soy Broth 500g |
| NCM0020A | Tryptone Soy Agar 500g |
| NCM0021A | Xylose Lysine Deoxycholate (XLD) Agar (ISO) 500g |
| NCM0022A | Violet Red Bile Glucose Agar (VRBGA) 500g |
| NCM0023A | Mueller Hinton Agar II 500g |
| NCM0024A | Baird-Parker Agar 500g |
| NCM0025A | Violet Red Bile Agar 500g |
| NCM0026A | Tryptic Soy Broth, Modified with Acid Digest of Casein 500g |
| NCM0027A | Xylose Lysine Deoxycholate (XLD) Agar 500g |
| NCM0028A | Corn Meal Agar 500g |
| NCM0029A | DRBC Agar (BAM) 500g |
| NCM0030A | Lauryl Sulfate Broth 500g |
| NCM0031A | Columbia Blood Agar Base 500g |
| NCM0032A | Lauryl Tryptose (LST) Broth 500g |
| NCM0033A | Nutrient Agar 500g |
| NCM0034A | Cystine Lactose Electrolyte Deficient (CLED) Agar 500g |
| NCM0035A | Lactobacilli MRS Agar 500g |
| NCM0037A | BCYE Agar (Legionella Isolation Medium) 500g |
| NCM0038A | Columbia Agar Base 500g |
| NCM0039A | Membrane Lauryl Sulphate Broth (500 g) |
| NCM0040A | Blood Agar Base No. 2 500g |
| NCM0041A | Violet Red Bile Glucose Agar (ISO) 500g |
| NCM0042A | Campy Blood-Free Selective Medium (Modified CCDA) – 500g |
| NCM0043A | Middlebrook 7H11 Agar 500g |
| NCM0044A | Universal Preenrichment Broth 500g |
| NCM0045A | GC Agar 500g |
| NCM0046A | Salmonella Shigella (SS) Agar 500g |
| NCM0047A | D/E Neutralizing Broth with Tween 500g |
| NCM0048A | Brilliant Green Bile 2% Broth – 500g |
| NCM0048A | Brilliant Green Bile 2% Broth – 500g |
| NCM0049A | PALCAM Broth – 500g |
| NCM0050A | Fraser Broth 500g |
| NCM0051A | Buffered Listeria Enrichment Broth 500g |
| NCM0052A | Thiosulfate Citrate Bile Salts Sucrose (TCBS) Agar 500g |
| NCM0053A | Acutone PPLO Broth w/o Crystal Violet – 500g |
| NCM0054A | Orange Serum Agar 500g |
| NCM0055A | Listeria Enrichment Broth 500g |
| NCM0056A | Oxford Listeria Agar 500g |
| NCM0058A | Brilliant Green Agar (Modified) 500g |
| NCM0059A | YM Broth – 500g |
| NCM0060A | MacConkey Broth 500g |
| NCM0061A | Todd Hewitt Broth 500g |
| NCM0062A | Bacillus cereus MYP Agar – 500g |
| NCM0063A | Tryptic Soy Broth, Modified with Novobiocin 500g |
| NCM0064A | Violet Red Bile Agar with MUG (VBRA-MUG) 500g |
| NCM0065A | EC Broth 500g |
| NCM0066A | Fraser Broth Base 500g |
| NCM0067A | Modified Semi-solid Rappaport-Vassiladis (MSRV) Agar 500g |
| NCM0068A | Sabouraud Dextrose Agar with Chloramphenicol 500g |
| NCM0069A | Yeast Extract Agar 500g |
| NCM0070A | Eugon Broth 500g |
| NCM0071A | Lauryl Sulfate Broth w/ MUG – 500g |
| NCM0072A | MacConkey Agar without Crystal Violet and Salt 500g |
| NCM0073A | Dextrose Tryptone Broth – 500g |
| NCM0074A | KF Streptococcus Agar – 500g |
| NCM0075A | Blood Agar Base 500g |
| NCM0076A | R2A Agar 500g |
| NCM0077A | Perfrigens Agar Base (TSC) 500g |
| NCM0078A | Mannitol Salt Agar – 500g |
| NCM0079A | Lactobacilli MRS Broth 500g |
| NCM0080A | Brain Heart Infusion Agar – 500g |
| NCM0081A | Dichloran Glycerol (DG-18) Agar Base 500g |
| NCM0082A | DRBC Agar (ISO) 500g |
| NCM0083A | Pseudomonas Agar Base 500g |
| NCM0084A | Modified Buffered Peptone Water with Pyruvate – 500g |
| NCM0085A | Maximum Recovery Diluent (Tryptone Salt Broth) 500g |
| NCM0086A | Bismuth Sulfite Agar 500g |
| NCM0087A | Tryptose Broth – 500g |
| NCM0088A | LB Broth (Miller) 500g |
| NCM0089A | Violet Red Bile Agar (VRBA) (ISO) – 500g |
| NCM0090A | Brucella Agar – 500g |
| NCM0091A | TAT Broth – 500g |
| NCM0092A | Tetrathionate Broth Base 500g |
| NCM0093A | Malt Extract Agar 500g |
| NCM0094A | Campylobacter Enrichment Broth (Bolton Broth) 500g |
| NCM0095A | Sabouraud Dextrose Agar (with Lecithin & Tween) – 500g |
| NCM0096A | Peptone Water 500g |
| NCM0098A | Tryptic Soy Blood Agar Base No. 2 – 500g |
| NCM0099A | Campy Cefex Agar – 500g |
| NCM0101A | TSB, Modified w/ 8mg/L Novobiocin & ADC – 500g |
| NCM0102A | Reinforced Clostridial Medium 500g |
| NCM0103A | Rappaport Vassiliadis Salmonella Enrichment Broth 500g |
| NCM0104A | Letheen Broth with Tween, Modified – 500g |
| NCM0105A | Eosin Methylene Blue (EMB) Agar Levine 500g |
| NCM0106A | Wilkins-Chalgren Agar – 500g |
| NCM0107A | EC Medium w/ MUG – 500g |
| NCM0108A | Fluid Thioglycollate Medium 500g |
| NCM0109A | Cetrimide Agar 500g |
| NCM0110A | Nutrient Broth 500g |
| NCM0111A | Palcam Agar Base 500g |
| NCM0112A | DC Medium with BCIG – 500g |
| NCM0113A | PPLO Broth Base without Crystal Violet 500g |
| NCM0115A | Columbia CNA Agar – 500g |
| NCM0116A | Letheen Broth (with Tween) – 500g |
| NCM0117A | Bile Esculin Agar 500g |
| NCM0118A | WL Nutrient Agar 500g |
| NCM0119A | Milk Plate Count Agar 500g |
| NCM0120A | Casein Peptone Type I – 500g |
| NCM0121A | D/E Neutralizing Broth without Tween 500g |
| NCM0122A | Presence Absence Broth – 500g |
| NCM0123A | m-Endo Agar – 500g |
| NCM0124A | A-1 Medium – 500g |
| NCM0125A | M Broth – 500g |
| NCM0126A | Muller-Kauffmann Tetrathionate-Novobiocin (MKTTn) Broth 5 |
| NCM0127A | Dextrose Tryptone Agar 500g |
| NCM0128A | Clostridium Diffcile Agar Base (Brazier’s) 500g |
| NCM0129A | Letheen Broth Base Modified without Tween – 500g |
| NCM0130A | Letheen Agar Base Modified without Tween – 500g |
| NCM0131A | GC Agar II- 500G |
| NCM0132A | OGYE Agar Base 500g |
| NCM0133A | Brilliant Green Agar w/ Sulfapyridine – 500g |
| NCM0134A | M-Green Yeast and Fungi Broth 500g |
| NCM0135A | Rose Bengal Chloramphenicol Agar 500g |
| NCM0136A | Rappaport-Vassiliadis Medium with Soya (RVS) (ISO) – 500g |
| NCM0137A | TSB Modified w/20mg Novobiocin & Acid Digest Casein – 500 |
| NCM0138A | Dermatophyte Test Medium (DTM) 500g |
| NCM0139A | Pancreatic Digest of Gelatin – 500g |
| NCM0140A | Lysine Iron Agar 500g |
| NCM0141A | Casman Medium Base – 500g |
| NCM0142A | LB Agar (Miller) 500g |
| NCM0143A | Tetrathionate (TT) Broth Base, Hajna 500g |
| NCM0144A | Triple Sugar Iron (TSI) Agar 500g |
| NCM0145A | Letheen Broth Base (no Tween) – 500g |
| NCM0146A | Tryptose 500g |
| NCM0147A | Sabouraud Dextrose Broth 500g |
| NCM0148A | Tryptose Phosphate Broth 500g |
| NCM0149A | mFC Agar – 500g |
| NCM0150A | Pseudomonas Isolation Agar – 500g |
| NCM0152A | Glucose OF Medium – 500g |
| NCM0153A | Phenylethanol Agar – 500g |
| NCM0154A | Schaedler Agar – 500g |
| NCM0155A | HC Agar Base – 500g |
| NCM0156A | Buffered Sodium Chloride-Peptone Broth pH 7.0 500g |
| NCM0157A | Potato Dextrose Broth – 500g |
| NCM0158A | Tryptone Glucose Extract (TGE) Agar 500g |
| NCM0159A | APT Agar – 500g |
| NCM0160A | MacConkey Agar without Crystal Violet 500g |
| NCM0161A | DNase Agar 500g |
| NCM0162A | Columbia Broth – 500g |
| NCM0163A | m-Enterococcus Agar – 500g |
| NCM0164A | Buffered Listeria Enrichment Broth Base 500g |
| NCM0165A | Bacillus cereus Agar Base (PEMBA) 500g |
| NCM0166A | Bile Esculin Azide Agar – 500g |
| NCM0167A | Sorbitol MacConkey Agar 500g |
| NCM0168A | Simmons Citrate Agar – 500g |
| NCM0170A | LB Agar, Lennox – 500g |
| NCM0171A | Universal Beer Agar – 500g |
| NCM0172A | Selenite Broth – 500g |
| NCM0173A | LB Broth, Lennox – 500g |
| NCM0174A | MacConkey Agar No. 3 – 500g |
| NCM0175A | Alkaline Saline Peptone Water (ASPW) (ISO) 500g |
| NCM0176A | Yeast & Mold Agar – 500g |
| NCM0177A | Urea Broth Base – 500g |
| NCM0178K1 | Ammonium Chloride-11g |
| NCM0178K2 | Ammonium Chloride-55g |
| NCM0179A | Minerals Modified Glutamate Agar (MMGA) – 500g |
| NCM0180A | Urea Agar Base (Christensen’s Urea Agar Base) – 500g |
| NCM0181K1 | Sodium Glutamate-130g |
| NCM0182A | Yersinia Selective Agar (Schiemann’s CIN Agar) 500g |
| NCM0183A | DRCM – 500g |
| NCM0184A | Modified Giolitti & Cantoni Broth – 500g |
| NCM0185A | Water Plate Count Agar – 500g |
| NCM0187A | Yeast Extract Dextrose Chloramphenicol Agar 500g |
| NCM0188A | R2A Broth – 500g |
| NCM0189A | Nutrient Broth No. 2 – 500g |
| NCM0190A | MRS Agar – 500g |
| NCM0191K | Ringer Solution 1/4 Strength Tablets (x100) |
| NCM0192A | Raka-Ray No. 3 Agar – 500g |
| NCM0193A | MacConkey Broth Purple – 500g |
| NCM0194A | MacConkey Agar No. 2 – 500g |
| NCM0195A | Campy Blood-Free Selective Medium (Modified CCDA)(EMEA) |
| NCM0196A | O157 Broth (Modified TSB) – 500g |
| NCM0197A | Slanetz & Bartley Agar – 500g |
| NCM0198A | Kanamycin Aesculin Azide Agar – 500g |
| NCM0199A | Fastidious Anaerobe Broth – 500g |
| NCM0200A | Baird Parker Agar Base – 500g |
| NCM0201A | LEE Broth – 500g |
| NCM0203A | Agar, Bacteriological (American Type) No. 2 – 500g |
| NCM0204A | Gelatin – 500g |
| NCM0205A | Agar, Technical – 500g |
| NCM0206A | Skim Milk, Agglomerated NFDM – 500g |
| NCM0207A | Malt Extract – 500g |
| NCM0208A | Beef Extract Powder – 500g |
| NCM0209A | Burkholderia Cepacia Selective Agar (BCSA) Complete- 500G |
| NCM0210A | Bile Salts No. 3 – 500g |
| NCM0211A | Tryptone No. 1 – 500g |
| NCM0213A | Meat Peptone No. 1 – 500g |
| NCM0214A | Agar, Bacteriological (American Type) No. 1 – 500g |
| NCM0215A | Casein Digest – 500g |
| NCM0216A | Dextrose, Anhydrous – 500g |
| NCM0217A | Yeast Extract, Ultra-Filtered-500G |
| NCM0219A | Wilkins-Chalgren Broth – 500g |
| NCM0220A | CLED Medium (Bevis Modification) – 500g |
| NCM0221A | Iron Sulphite Agar – 500g |
| NCM0222A | Nutrient Agar 1.5% – 500g |
| NCM0223A | Phosphate Buffer, pH 7.2 – 500g |
| NCM0224A | Reinforced Clostridial Agar – 500g |
| NCM0225A | Wort Agar – 500g |
| NCM0226A | Kligler Iron Agar – 500g |
| NCM0227A | Cronobacter Selective Broth – 500g |
| NCM0228A | Pancreatic Digest of Soy No. 1 – 500g |
| NCM0229A | Enzymatic Digest of Soy No. 2 – 500g |
| NCM0230A | Oxbile (Oxgall) – 500g |
| NCM0231A | Sucrose – 500g |
| NCM0232A | Meat Peptone No. 4 – 500g |
| NCM0233A | Lactose – 500g |
| NCM0235A | Cycloheximide – 500g |
| NCM0236A | Agar, Bacteriological (European Type) No.1 – 500g |
| NCM0237A | Soy Peptone – 500g |
| NCM0238A | Agar, Bacteriological (European Type) No. 2 – 500g |
| NCM0239A | Acid Hydrolysed Casein – 500g |
| NCM0241A | Glucose (Dextrose) – 500g |
| NCM0242A | Mannitol (D-Mannitol) – 500g |
| NCM0243A | Gelatin Powder – 500g |
| NCM0244A | Sodium Thiogylcollate – 500g |
| NCM0245A | Sodium Chloride (Bacteriological) – 500g |
| NCM0246A | Meat Peptone No. 3 – 500g |
| NCM0247A | Maltose, Monohydrate – 500g |
| NCM0248A | Sodium Deoxycholate- 500g |
| NCM0249A | Skim Milk Powder – 500g |
| NCM0250A | Agar No. 4 – Plant Tissue Culture Grade – 500g |
| NCM0251A | Liver Digest – 500g |
| NCM0252A | Lactalbumin Hydrolysate – 500g |
| NCM0253A | Lecithin – 500g |
| NCM0257A | Balanced Peptone No. 1 – 500g |
| NCM0258A | Mycological Peptone – 500g |
| NCM0259A | Bacteriological Peptone – 500g |
| NCM0260A | Tryptose No. 2 – 500g |
| NCM0261A | B-Pep CCT/ET 01 – 500g |
| NCM0262A | M-Pep CCT/ET 01 – 500g |
| NCM0263A | C-Pep CCT/ET 01 – 500g |
| NCM0264A | B-Pep CCT/ET 02 – 500g |
| NCM0265A | Sugar Free Agar – 500g |
| NCM0266A | m-TGE Broth – 500g |
| NCM0267A | Meat Peptone No.2 (500 g) |
| NCM0268A | Perfringens Agar (OPSP) – 500g |
| NCM0269A | Nutrient Agar (BAM) – 500g |
| NCM0270A | Buffered Peptone Water HQ (ISO) – 500g |
| NCM0271A | EC Medium, Modified w/ Novobiocin – 500 G |
| NCM0272A | Sabouraud Dextrose Agar, Emmons – 500 G |
| NCM0284A | m-HPC Agar – 500 G |
| NCM0286A | 2% Malt Extract Agar 500g |
| NCM0289A | MSRV ( Legacy 7511) – 500g |
| NCM0290A | GN Broth (Hajna) – 500 g |
| NCM0292A | Acid Digest of Casein – 500 G |
| NCM0900A | Acuferm Proteose Peptone #3 – 500 G |
| NCM0901A | Acuferm Peptone – 500 G |
| NCM0902A | Acuferm Neopeptone – 500 G |
| NCM0903A | Acutone Tryptic Soy Broth (Non-Animal TSB) – 500g |
| NCM0904A | Acutone Tryptose Phosphate Broth ( Non-Animal TPB) – 500 |
| NCM0905A | Acuferm Soytone, Advanced – 500 g |
| NCM1001A | Harlequin Tryptone Bile Glucuronide Agar (TBX) 500g |
| NCM1002A | Harlequin E. coli/Coliform Agar – 500g |
| NCM1004A | Harlequin Listeria Cromogenic Agar (Ottaviani&Agosti) – 500 |
| NCM1005A | Harlequin Cromogenic Coliform Agar – 500g |
| NCM1006A | Harlequin Chromogenic Agar for Salmonella Estrarase-500g |
| NCM1006S | Harlequin Chromogenic Agar for Salmonella Estrarase-49.9g |
| NCM1008A | Harlequin Cronobacter Isolation Agar – 500 G |
| NCM1009A | Harlequin mLGA – 500 G |
| NCM2037A | Brain Heart Infusion Broth ( legacy 7116) – 500g |
| NCM4006-2.5 | BCYE Growth Supplement (10 x 2.5L) |
| NCM4007-0.5 | GVPC Selective Supplement (10 x 500mL) |
| NCM4008-0.5 | CN Supplement (10 x 500mL) |
| NCM4009-0.5 | Ferric Ammonium Citrate (10 x 500mL) |
| NCM4010-100 | Egg Yolk Tellurite (1x100mL) |
| NCM4011-1 | Lactic Acid 10% (10 x 1mL) |
| NCM4012-10 | Potassium Tellurite 1% (10 x 10mL) |
| NCM4017-100 | Egg Yolk Emulsion 50% (1 x 100mL) |
| NCM4018-0.5 | Polymyxin B (10x 500mL) |
| NCM4018-8.0 | Polymyxin B (10 x 8L) |